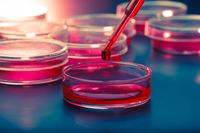

قائمة التقنيات الناشئة
قائمة التقنيات الناشئة، وتستعرض أبرز ما شهدته العلوم والتقنية من تقدم وابتكار في المجالات التكنولوجية المختلفة. والتقنيات التكنولوجية الناشئة هي تلك الابتكارات التقنية التي تمثل خطوة تقدمية في مجال معين وتحقق ميزة تنافسية على ما عداها من التقنيات السائدة. وتتفاوت الآراء حول جدوى وأهمية وحالة التقنيات الناشئة المختلفة وصلاحيتها الاقتصادية.
الطيران
| التقنية الناشئة | صورة | الحالة | قد تحل محل | التطبيقات المحتملة | مقالات متعلقة |
|---|---|---|---|---|---|
| المركبة الجوية الصغروية Micro air vehicle |
نماذج أولية | الاستطلاع الداخلي السري، تجسس "الطيران-على-الحائط"، العمل في الأماكن الضيقة التي يصعب الوصول إليها | مركبة جوية غير مأهولة (Unmanned aerial vehicle)، محاكاة حيوية (Biomimetics) | ||
| سماعة الاستشعار العصبي (الاستشعار والتوصيف عبر الجمجمة).[1] Neural-sensing headset (trans-cranial neural sensing and characterization) |
البحث والتطوير | سماعات الرأس التقليدية | مساعدة الطيارين | حاسوب العقل الوسيط، أطراف تعويضية عصبية (neuroprosthetics | |
| القيادة الأيونية Ion drive |
قيد الاستخدام[2] | دفع المركبات الفضائية | |||
| محركات دفع الپلازما Plasma propulsion engines |
البحث والتنمية | دفع المركبات الفضائية |
الانشاءات
| التقنية الناشئة | صورة | الحالة | قد تحل محل | التطبيقات المحتملة | مقالات متعلقة |
|---|---|---|---|---|---|
| Claytronics | افتراضية، تجريبية | طرق وأدوات التصنيع التقليدية للطباعة ثلاثية الأبعاد | |||
| طباعة رباعية الأبعاد Four-dimensional printing |
البحث والتطوير | طرق وأدوات التصنيع التقليدية للطباعة ثلاثية الأبعاد | |||
| مجمع جزيئي Molecular assembler |
افتراضي، التجربة | طرق وأدوات التصنيع التقليدية للطباعة ثلاثية الأبعاد | Replicator (Star Trek), Von Neumann universal constructor | ||
| مولد الضباب Utility fog |
افتراضية، التجربة | ||||
| الطباعة المعدنية رباعية الأبعاد Four-dimensional printing |
التطوير، النماذج الأولية | إنتاج قطع أخف وزناً وأكثر قوة، شرائح معقدة لا يمكن إنتاج بالطرق التقليدية لتصنيع المعادن[3] |
العمارة
| التقنية الناشئة | صورة | الحالة | قد تحل محل | التطبيقات المحتملة | مقالات متعلقة |
|---|---|---|---|---|---|
| العمارة البيئية Arcology |
البحث، التطوير، التسويق التجاري | ||||
| المدينة المقببة Domed city |
جاري بنائها في دبي[4] مشروع مول العالم الذي تم تقليصه | التحكم في طقس المدينة، والوقاية من دخول أي أجسام أو كائنات غير مرغوب فيها،
وغيرها. |
علوم المواد
| التقنية الناشئة | صورة | الحالة | قد تحل محل | التطبيقات المحتملة | مقالات متعلقة | |
|---|---|---|---|---|---|---|
| الهلام الهوائي Aerogel |
افتراضي، التجارب، الانتشار، استخدامات مبكرة[5] | العزل التقليدي ، الزجاج | العزل المحسن، الزجاج العازل إذا ما تم صنعه بدرجة نقاء عالية، عزل أنابيب نقل النفط، الفضاء الجوي، تطبيقات البيئات شديدة البروة أو شديدة الحرارة | |||
| فلز غير بلوري Amorphous metal |
التجارب | كڤلار | تصفيح | |||
| البلاستيك الحيوي Bioplastic |
تم تطوير بعض المنتجات | بلاستيك الوقود الحيوي | ||||
| الپوليمرات الموصلة Conductive polymers |
البحث، التجار، النماذج الأولية | الموصلات | أسلاك أخف وأرخص سعراً، مواد إستاتيكية، الخلايا الشمسية العضوية | منسج الجاكار | ||
| المعالجة بالتبريد العميق Cryogenic treatment |
الأبحاث، التجارب، النماذج الأولية | المعادن، مركبات المصفوفة المعدنية، هجين المعادن والزجاج وB4C | واقيات انفجار النفط والزجاج، المحركات النفاثة، توربينات الطاقة، القاطرات، المركبات الكهربائية، التروس والمحامل | |||
| الفولرين Fullerene |
التجارب، الانتشار | الماس الاصطناعي، أنابيب الكربون النانوية (مثل ورق البوكي) | المواد القابلة للبرمجة | |||
| الگرافين Graphene |
افتراضية، التجارب، الانتشار، استخدامات أولية[6][7] | الدائرة المتكاملة المصنوعة من السليكون | مكونات أكثر قوة مقارنة بالوزن، الترانزيستورات التي تعمل بتردد عالي، شاشات العرض منخفضة التكلفة في أجهزة المحمول، تخزين الهيدروجين من أجل السيارات التي تعمل بخلية الوقود، المناظير لتشخيص الأمراض، بطاريات أكثر كفاءة[8] | |||
| مختبر على رقاقة Lab-on-a-chip |
بعض التسويق التجاري | مختبرات التحاليل | ||||
| الموصلية الفائقة مرتفعة الحرارة High-temperature superconductivity |
واجهات الاستقبال الأمامية لأجهزة التبريد العميق (CRFE)، أنظمة مرشح الترددات الراديو والموجات الصغروية للمحطات التي يتم بثها من على الهواتف المحمولة؛ نماذج أولية في الثلج الجاف؛ افتراضية وتجارب في درجات الحرارة العليا[9] | الأسلاك النحاسية، الدوائر المدمجة في أشباه الموصلات | الحفاظ على أشباه الموصلات، محامل بلا احتكاك، التعليق المغناطيسي، الحفاظ على المراكم عالية الطاقة، الدوائر والمعالجات المدمجة heat-free | |||
| السائل الريو-مغناطيسي | التطوير والبحث | ممتص الصدمات | Magnetorheological damper heavy motor damping, operator seat/cab damping in construction vehicles, seismic dampers positioned in building absorbing detrimental shock waves and oscillations within the structure making them earthquake-proof, enhance body armour fluid bullet resistant, Humvees, and various other all-terrain vehicles employ dynamic MR shock absorbers/dampers. Magnetorheological finishing was used in the construction of the Hubble Space Telescope's corrective lens, shock absorbers of a vehicle's suspension are filled with magnetorheological fluid. | سائل إلكترويولوجي | ||
| ميوعة فائقة مرتفعة الحرارة High-temperature superfluidity |
الجيوسكوبات فائقة الميوعة موجودة بالفعل لكنها تعمل على درجات حرارة منخفضة للغاية | الجيروسكوبات، الحدافة | قياس الجاذبية عالي الدقة، أجهزة الملاحة والمناورة، أجهزة محتملة لبث مجال مغناطيسية جاذبية، أجهزة ميكانيكية عديمة الاحتكاك | |||
| المواد الخارقة Metamaterials |
افتراضية، التجارب، الانتشار [10] | البصريات الكلاسيكية | المجهار، الكاميرات، إخفاء المواد الخارقة، أجهزة الإخفاء | |||
| الرغوة المعدنية Metal foam |
البحث، التسويق التجاري | هياكل السفن | مستعمرات الفضاء، المدن الطافية | |||
| الهياكل متعدد الوظائف Multi-function structures[11] |
افتراضية، التجارب، بعض النماذج الأولية، الانتشار التجاري المحدود | مواد مؤلفة في الغالب | نطاق عريض، مراقبة الصحة الذاتية، مادة ذاتية الإصلاح، التحويل | |||
| المواد النانوية Nanomaterials: أنابيب الكربون النانوية carbon nanotubes |
افتراضية، التجارب، الانتشار، استخدامات مبكرة[12][13] | الصلي والألومنيوم الهيكلي | مواد أقوى وأخف، مصعد الفضاء | التطبيقات المحتملة لأنابيب الكربون النانوية، ألياف الكربون | ||
| المواد القابلة للبرمجة Programmable matter |
افتراضية، التجارب[14][15] | التغطيات، المحفزات | نطاق عريض، claytronics، علم الأحياء التركيبي | |||
| النقاط الكمومية Quantum dots |
الأبحاث، التجارب، النماذج الأولية[16]، تم تسويقها تجارياً | LCD، LED | ليزر النقطة الكمومية، شاشة النقطة الكمومية، استخدامها مستقبلياً كمادة قابلة للبرمجة في تقنيات العرض (التلفزيون، البروجكتور)، اتصالات البيانات البصرية (نقل البيانات عالي السرعة)، الطب (مشرط الليزر) | |||
| السيلسين Silicene |
افتراضي، الأبحاث | الترانزستورات المتأثرة بالمجال المغناطيسي | ||||
| السبيكة الفائقة Superalloy |
الأبحاث، الانتشار | الألومنيوم، التيتانيوم، المواد التركيبية | محركات الطائرات النفاثة | |||
| الماس الاصطناعي Synthetic diamond |
الأبحاث، التسويق التجاري | ترانزستورات السليكون | الإلكترونيات | |||
| بلورات الزمن Time crystals |
التجارب البحثية[17] | الحواسب الكمومية الحالية | حواسب كمومية ذات بت كمومي مستقر | |||
| خرسانة نصف شفافة Translucent concrete |
التسويق التجاري | الزجاج | إنشاء ناطحات السحاب، الأبراج، الأعمال النحتية مثل بوابة أوروپا | |||
| السبيكة فائقة الانصهار Hypereutectic alloy |
البحث، التسويق التجاري | الصب | المعادن | المكابس فائقة الانصهار | ||
| سبيكة البلاستيك الفائقة Super-plastic alloy |
البحث، التسويق التجاري | الصب | المعادن | اللدونة الفائقة |
شاشات العرض
الإلكترونيات
الطاقة
| التقنية الناشئة | صورة | الحالة | قد تحل محل | التطبيقات المحتملة | مقالات متعلقة |
|---|---|---|---|---|---|
| عنفات الرياح المحمولة جواً Airborne wind turbine |
البحث[43][44][45] | الوقود الأحفوري | إنتاج الكهرباء | كايتجن | |
| التمثيل الضوئي الاصطناعي Artificial photosynthesis |
البحث، التجارب[46] الاهتمام المتزايد في مشروع عالمي للعلوم المكروية[47] | التمثيل الضوئي المحفوظ Agricultural robot |
تحسين التمثيل الضوئي الطبيعي، وبالتالي يمكن للمباني والمركبات على الطرق تحويل ضوء الشمس والمياه إلى هيدروجين وثاني أكسيد الكربون وإلى كربوهيدرات. | التنمية المستدامة، الطاقة المتجددة، تقنية النانو | |
| الطاقة الشمسية المركزة Concentrated solar power |
تزايد الأسواق في الولايات المتحدة، إسپانيا، شمال أفريقيا[48] | الوقود الأحفوري، الخلايا الفولطية الضوئية | إنتاج الكهرباء | ديزرتك، برايتسورس للطاقة، سولار ملينيوم | |
| المعالجة بالتبريد العميق Cryogenic Treatment |
استخراج النفط والغاز من قاع البحر والمياه العميقة؛ توليد الكهرباء من الرياح والوقود الأحفوري، الطاقة النووية | المعادن، المركبات المعدنية، هجين المعادن الزجاجية وB4C | موانع انفجار الزجاج والغاز (BOP)، المحركات النفاثة، توربينات الطاقة، القاطرات، المركبات الكهربائية، التروس والمحامل | مؤسسات علوم التقنيات الناشئة | |
| المكثف الكهربائي مزدوج الطبقة Electric double-layer capacitor |
الانتشار، التطوير المستمر[49] | البطاريات الكيميائية | Regenerative braking؛ تخزين الطاقة: شحن أسرع، أكثر بقاءاً، أكثر مرونة وصديق للبيئة | ||
| حصاد الطاقة Energy harvesting |
التجارب | البطاريات | مصدر طاقة ثابت لمحمول، أجهزة يمكن ارتداؤها وفي أي مكان | هوماڤوكس | |
| حدافة تخزين الطاقة Flywheel energy storage |
بعض النماذج التجارية | ||||
| طاقة الانصهار Fusion power |
افتراضية، التجارب | الوقود الأحفوري، الطاقة المتجددة، طاقم الانصهار النووي | انتاج الكهرباء، التدفئة، اعادة تدوير شعلة الانصهار مع تسخين النفايات | ITER، NIF، پوليول، تركيز الپلازما الكثيفة، الانصهار المحفز بالمون، وندلشتاين 7-إكس | |
| مفاعل الجيل الرابع Generation IV reactor |
البحث، التجارب | مفاعلات الطاقة النووية التقليدية، الوقود الأحفوري | انتاج الكهرباء، التدفئة، تحويل مخزون النفايات النووية من المفاعلات التقليدية | ||
| تخزين طاقة الشبكات Grid energy storage |
الاستخدام في تزايد | ||||
| خلية الوقود المنزلي Home fuel cell |
البحث، التسويق التجاري[50][51][52] | الشبكة الكهربائية | خارج الشبكة، انتاج الكهرباء | المباني المستقلة ذاتياً، خادم بلوم للطاقة | |
| بطارية ليثيوم-هواء Lithium-air battery |
الأبحاث، التجارب[53] | الطرق الأخرى لتخزين الطاقة: الهيدروجين، البطاريات الكيميائية، وبعض استخدامات الوقود الأحفوري | الحواسب المحمولة، الهواتف المحمولة، السيارات الكهربائية طويلة المدى؛ تخزين الطاقة للشبكات الكهربائية | ||
| بطارية فوسفات-حديد-ليثيوم Lithium iron phosphate battery |
التسويق التجاري | ||||
| بطارية كبريت-ليثيوم Lithium–sulfur battery |
البحث والتطوير | ||||
| بطارية المغنسيوم Magnesium battery |
التسويق التجاري المبكر | بطارية أيون الليثيوم | |||
| مفاعل الملح المنصهر Molten salt reactor |
البحث، التجارب | مفاعلات الطاقة النووية التقليدية، الوقود الأحفوري | انتاج الكهرباء، التدفئة | ||
| بطارية السلك النانوي Nanowire battery |
التجارب، نماذج أولية[54][55] | الطرق الأخرى لتخزين الطاقة: الهيدروجين، البطاريات الكييمائية، بعض استخدامات الوقود الأحفوري | الحواسب المحمولة، الهواتف المحمولة، السيارات الكهربائية طويلة المدى؛ تخزين الطاقة للشبكات الكهربائية | ||
| الهوائي النانوي Nantenna |
البحث[56][57][58] | الوقود الأحفوري | انتاج الكهرباء | ||
| تحويل الطاقة الحرارية للمحيط Ocean thermal energy conversion |
نموذج أولي | ||||
| الشبكة الذكية Smart grid |
البحث، الانتشار[59][60][61] | العداد الذكي، الشبكة الذكية الفائقة | |||
| الطاقة الشمسية الفضائية Space-based solar power |
افتراضية | ||||
| دورة وقود الثوريوم Thorium fuel cycle |
بدأت الأبحاث في الستينيات، ولا تزال مستمرة | الطاقة النووية المعتمدة على اليورانيوم، الوقود الأحفوري | انتاج الكهرباء، التدفئة | ||
| المحرك الدوامي Vortex engine |
المدخنة برج التبريد، البرج الشمسي | توليد الطاقة | |||
| ناقل الطاقة اللاسلكي Wireless energy transfer |
نماذج أولية، الانتشار، عدد قليل من السلع الاستهلاكية[62][63] | الأسلاك الكهربائية، المقابس، البطاريات | الأجهزة التي تعمل بالطاقة اللاسلكية: الحواسب المحمولة، الهواتف الذكية، السيارات الكهربائية،... الخ | ويتريسيتي، خاصية الرنين الكهربائية | |
| بناء صفر طاقة Zero-energy building |
التوسع | شبكات الكهرباء ومصانع الطاقة | جميع المنازل | منزل إيجابي |
الترفيه
| التقنية الناشئة | صورة | الحالة | قد تحل محل | التطبيقات المحتملة | مقالات متعلقة |
|---|---|---|---|---|---|
| الصور المنشأة بالحاسوب Computer-generated imagery |
التطوير | نماذج الصور، جميع الأعمال المتعلقة بالأفلام (تشمل إعلانات الخدمة العامة، الڤيديوهات الموسيقية، الڤيديوهات الڤيروسية، التجارية والإباحية)، باستثناء المخرجين، كتاب السيناريو ومصممي الگرافيك[64] | الأفلام، الصور | ||
| Immersive virtual reality | افتراضي، تسويق تجاري محدود | الواقع التوافقي | البيئة الاصطناعية حيث يشعر المستخدم أنه مغمور تماماً كما يشعر عادة في الواقع التوافقي. | Virtusphere, 3rd Space Vest, haptic suit, immersive technology, simulated reality, holodeck (خيالي) | |
| التلفزيون فائق الدقة Ultra-high-definition television |
تم تسويقه تجارياً | التلفزيون عالي الدقة |
المعلومات وتكنولوجيا المعلومات
| التقنية الناشئة | صورة | الحالة | قد تحل محل | التطبيقات المحتملة | مقالات متعلقة |
|---|---|---|---|---|---|
| الجيل الخامس لاتصالات المحمول 5G |
البحث والتطوير | تطوير طويل الأمد (الجيل الرابع) | الهواتف الذكية، الحواسب اللوحية | ||
| الذكاء المحيطي Ambient intelligence |
افتراضي | ||||
| الدماغ الاصطناعي Artificial brain |
البحث[65] | الدماغ البشري | علاج الأمراض العصبية، الذكاء الاصطناعي | مشروع الدماغ الأزرق، مشروع الدماغ البشري | |
| الذكاء العام الاصطناعي Artificial general intelligence |
افتراضي، التجارب؛ [66][67][68] | اتخاذ القرار البشري، التحليل، ...الخ. | تصنيع الأجهزة الذهية والروبوت؛ يمكن استخدام الذكاء الاصطناعي للتشاور (أو حتى تولي المسؤولية) في المشروعات العلمية، الحكومات، الجيش، حوكمة المؤسسات، صناعة السينما والكتب، الاختراعات، ...ألخ. | التقدم في الذكاء الاصطناعي، التفرد التكنولوجي، تطبقات الذكاء الاصنطاعي | |
| Atomtronics | افتراضي | ||||
| الواقع المعزز Augmented reality |
الانتشار | نظارة گوگل، ويندوز الواقع المختلط، واقع مختلط، النظارة الذكية | |||
| سلسلة الكتل Blockchain أو التكنولوجيا الدفترية الموزعة[69] |
الانتشار | الوسطاء المحترفون | القضاء على أو تخفيض تكاليف المعاملات؛ الاحتفاظ بتوزيع، علانية وشفافية السجلات؛ أنظمة الشبكات الغير هرمية؛ التعمية[70] | بتكوين، العملة الرقمية، العملة المشفرة، الديمقراطية الإلكترونية | |
| Carbon nanotube field-effect transistor | البحث والتطوير | ترانزستور السليكون | تمديد قانون مور | ||
| التكنولوجيا المدنية Civic technology |
البحث والتطوير، المشروعات | المدن الذكية، حكومات أكثر استجابة | التكنولوجيا المدنية، المدينة الذكية، الديمقراطية الإلكترونية، البيانات المفتوحة، الذكاء، البيئة | ||
| Counterparty (technology) | الانتشار | المراهنة، سوق الأوراق المالية، الصرافة المركزية | الأدوات المالية اللامركزية،[71] القمار، الأسواق الحرة | بيتكوين، العملة المعماة، العملة الرقمية | |
| العملة المعماة Cryptocurrency |
الانتشار | الصرافة المركزية | المعروض النقدي، احتياطي العملات العالمي | بيتكوين، العملة الرقمية | |
| تخزين البيانات الرقمية للدنا DNA digital data storage |
التجارب | تخزين البيانات الضخمة | |||
| Exascale computing | مشروعات | ||||
| التعرف الحركي Gesture recognition |
الانتشار | الفأرة، لوحة المفاتيح، شاشات اللمس | |||
| إنترنت الأشياء Internet of Things |
الانتشار | ||||
| تقنيات الذاكرة الناشئة Emerging memory technologies |
قيد التطوير | تقنيات الذاكرة الحالية | T-RAM, memristor, Z-RAM, TTRAM, CBRAM, SONOS, RRAM, Racetrack memory, NRAM, Phase-change memory, FJG RAM, Millipede memory, Skyrmion, Programmable metallization cell, 3D XPoint, Ferroelectric RAM, Magnetoresistive random-access memory, nvSRAM | ||
| تقنيات تخزين البيانات المغناطيسية الناشئة Emerging magnetic data storage technologies |
قيد التطوير (HAMR، BPM)؛ الانتشار (SMR) | كثافة تخزين محسنة بدرجة كبيرة عن HDDs الحالية، ويمكن الجمع بينها وبين | SMR، HAMR، BPM، MAMR، TDMR، CPP/GMR، PMR، القرص الصلب | ||
| الأقراص البصرية من الجيل الرابع Fourth-generation optical discs (تخزين البيانات البصرية ثلاثية الأبعاد، تخزين البيانات التجسيمية |
البحث، عمل النماذج الأولية[72] | بعض طرق/أجهزة التخزين الوفير، تخزين بيانات الشريط المغناطيسي، تخزين البيانات البصرية | تخزين وأرشفة البيانات التي كانت تمحى في السابق لأسباب اقتصادية | قرص بلو راي، التخزين البصري | |
| وحدات المعالجة المحوسبية للگرافيك ذات الغرض العام GPGPU |
انتشار الطرق الغير معيارية | وحدة المعالجة المركزية لعدد محدود من الاستخدامات المتخصصة | ترتيب حجم معالجة أسرع للخوارزميات المتوازية | ||
| إكسوكروتكس Exocortex |
انتشار التوسعات الأولية، العمل على المزيد من النماذج الأولية؛ افتراضي، التجارب على المزيد من التوسعات الأساسية | المكتبات، المدارس، التدريب، حاسبات الجيب | |||
| اللاي-فاي Li-Fi |
عرض، بحاجة لمعايير | شبكة الواي-فاي | |||
| الترجمة الآلية Machine translation |
الانتشار[73][74] | الترجمة البشرية للغات الطبيعة، في المناطق التي يكون فيها سوء الفهم غير منتقد وتكون اللغة رسمية | التواصل الأسرع والأرخص بين الثقافات | ||
| الرؤية الآلية Machine vision |
البحث، النماذج الأولية، التسويق التجاري[65] | الرؤية والإدراك الحيوي، ويشمل البشر | المقياس الحيوي، عمليات التحكم (كما في السيارات بلا قائد، المركبات الموجهة آلياً)، التحقق من الأحداث (كما في التجسس البصري)، التفاعل (كما في التفاعل بين البشر والحاسوب)، رؤية الروبوت | رؤية الحاسوب، التعرف النمطي، معالجة الصور رقمياً | |
| التعاون المحمول Mobile collaboration والتعليم الإلكتروني e-learning |
التطوير، التسويق التجاري[75] | نقل البشر، أنظمة مؤتمرات-الڤيديو التقليدية | زيادة القدرة على عقد مؤتمرات-الڤيديو لاستخدام أجهزة المحمول المحمولة باليد في الوقت الحقيقي عبر الشبكات الآمنة. للاستخدام في مختلف الصناعات مثل التصنيع، الطاقة، الرعاية الصحية.[76] العمل عن بعد | ||
| الراديو النانوي Nanoradio |
البحث، التطوير والانتشار | ناقلات ومستقبلات الراديو التقليدية | |||
| الحوسبة البصرية Optical computing |
افتراضية، التجارب؛ تم تطوير بعض مكونات الدوائر المدمجة[77] | الكثير من الأجهزة الإلكترونية، الدوائر المدمجة | الحوسبة الاستهلاكية الأصغر حجماً، الأسرع، والأقل استخدماً للطاقة | ||
| الحاسوب الكمومي Quantum computer |
افتراضية، التجارب[78] تجارية[79] | Atomtronics، الحوسبة الإلكترونية، الحوسبة البصرية، الساعة الكمومية |
الحوسبة الأكثر سرعة، لبعض أنواع المشكلات، النمذجة الكيميائية، المواد الجديدة ذات الخصائص القابلة للبرمجة، افتراضية في الموصلية الفائقة عالية الحرارة والميوعة الفائقة | ||
| التعمية الكمومية Quantum cryptography |
تجارية[80] | الاتصالات الآمنة | |||
| تحديد الهوية بموجات الراديو Radio-frequency identification |
الانتشار بتكاليف عالية[81][82][83] | ||||
| الباركود Barcode |
المتاجر الذكية - السداد الذاتي المعتمد على RFID (تتبع جميع المنتجات الواردة والصادرة)، تغليف الأغذية، الأرفف الذكية، البطاقات الذكية. انظر: الاستخدامات المحتملة | ||||
| الوب الدلالي Semantic Web أو الرد الآلي answer machine |
البحث، استخدام محدود | وب 2.0 | جعل الوب مقروءاً آلياً عن طريق وضع تعليقات توضيحية للبيانات على الويب استناداً إلى معناها | الودب الدلالي المؤسسي، خدمات الوب الدلالي، حزمة الوب الدلالي، وب 3.0 | |
| مكبر الصوت الذكي Smart speaker |
تجارياً | الهواتف الذكية، الحواسب | الأتمتة المنزلية، التواصل مع الأشخاص والآلات | أمازون إيكو، گوگل هوم، هومپود | |
| الراديو المعرف برمجياً Software-defined radio |
التطوير، تجارياً | دوائر الراديو محددة التردد التقليدية، أجهزة معالجة الإشارة المتخصصة | الراديو المعرفي، الشبكات العروية، الهوائي القابل للتشكل | راديو جنو، Universal Software Radio Peripheral | |
| تمييز الكلام Speech recognition |
البحث، التطوير، التسويق التجاري | أجهزة الإدخال الميكانيكية | |||
| التمييز الصوتي Subvocal recognition |
البحث، التطوير، تجارياً | ||||
| الواقع الافتراضي Virtual Reality |
الانتشار | الترفيه، التعليم | أوكولوس ريفت، إتش تي سي ڤايڤ، پلاي سيتشن ڤي آر | ||
| التحاليل الجنائية المختلطة Hybrid forensics[84] |
البحث، التسويق التجاري | التصوير الجنائي الرقمي، مؤشر إنشاء الاكتشافات الإلكترونية، استخدام "العملاء" الذين ينبغي إرسالهم عند نقاط معينة لجمع البيانات | الطب الشرعي الرقمي، الاكتشاف الإلكتروني، التحقق من البرمجيات الخبيثة، تكامل تكنولوجيا المعلومات |
الطب
| التقنية الناشئة | صورة | الحالة | قد تحل محل | التطبيقات المحتملة | مقالات متعلقة |
|---|---|---|---|---|---|
| الرحم الاصطناعي Artificial uterus |
افتراضية، البحث | الحاضنة، في المعمل الحمل، بما في ذلك الأمومة المضيفة | السفر الفضائي، الحمل خارج الجسم، علم الجينات الإنجابي، التنافس مثلي الجنس | ||
| مزروعات الجسم Body implants، الجراحة الترقيعية prosthesis |
تجريبية، من الحيوانات (مثل زراعات المخ) إلى البشر سريرياً (مثل زراعة مضخات الإنسولية)، إلى الإنتاج التجاري (مثل المنظمات، زراعة المفاصل، الزرع القوقعي) | مجالات طبية متعددة، الحروب | زراعة المخ، زراعة الشبكية | الجراحات الترقيعية، الجراحات الترقيعية في الخيال، سابورگ | |
| حفظ الخلايا الحية بالتبريد Cryonics |
افتراضية، الأبحاث، التسويق التجاري (مثل معهد حفظ الخلايا الحية بالتبريد) | المقابر | إطالة الحياة | ||
| إحياء الأنواع المنقرضة De-extinction |
البحث، التطوير، التجارب | تربية الماشية، الحيوانات الأليفة، حدائق الحيوانات | إعادة خلق الماموث الصوفي | ||
| الهندسة الوراثية للعضيات والڤيروسات Genetic engineering of organisms and viruses |
البحث، التطوير، التسويق التجاري[85][86] | إجراءات طبية أخرى وتشمل الطب التجميلي وتحديد النسل، الحروب التقليدية (الجنود المعدلة وراثياً، الأسلحة البيولوجية الأخلاقية)،[87] تربية الماشية وتهجين النباتات والفطريات التقليدية، فن الوشم وأندية اللياقة البدنية ومستحضرات التجميل والتغذة (لأن البشر ذوي الجينات الجديدة سيصبحوا قادرين على تغيير شكلهم عند الطلب)، تنسيق الحدائق (لأن الجينات الجديدة لن تكون بحاجة لتغذية النباتات)، جهود إنقاذ الأنواع (لأن الجينات الجديدة يمكن اعتمادها لبيئات جديدة)، إنتاج الوقود التقليدي[88][89] | خلق وتعديل الأنواع (وخاصة تحسين قدراتهم البدنية والعقلية)، الآلات الحيوية، علاج الاضطرابات الوراثية (علاج وراثي)، إنتاج المواد الجديدة،[90] أغذية أكثر صحة وأرخص ثمناً، تحضير الأدوية واللقاحات، الأبحاث في العلوم الطبيعية، المعالجة الحيوية،[91] الكشف عن الزرنيخ[92] | بيوپك، الطعام المعدل وراثياً، الرجل الخارق، التعزيز البشري، بعد إنسانية، التنشيط الوراثي، الطفل المصمم، التلوث الوراثي | |
| السبات الشتوي Hibernation أو الحياة المعلقة suspended animation |
البحث، التطوير، التجارب على الحيوانات[93] | التخدير الجراحي | زراعة الأعضاء، الرحلات الفضائية، الجراحات المطولة، رعاية الطوارئ | ||
| العلاج المناعي Immunotherapy - العلاج المناعي للأورام immuno oncology |
التسويق التجاري، البحث والتطوير | العلاج التقليدي للسرطان، العلاج الكيميائي، العلاج الإشعاعي، الجراحة | علم الأورام، علاجات السرطان (العلاج الأولي أو المجمع) باستخدام الاستجابات المناعية المستهدفة والفطرية. | مثبطات الحواجز (anti-pd-1, anti pd-L1, ctla-4), CAR-T, IDO inhibitors, Oncolytic virus/virotherapy (انظر أدناه) | |
| إطالة الحياة Life extension، استراتيجيات من أجل شيخوخة مستبعدة وراثياً Strategies for Engineered Negligible Senescence |
البحث، التطوير، الاختبار على الحيوانات[94][95] | الأدوية القائمة لعلاج الأمراض المرتبطة بالشيخوخة | إطالة العمر المتوقع | الخلود، الخلود الحيوي | |
| الطب النانوي Nanomedicine |
البحث، التجارب، الاستخدام المحدود[96][97] | ||||
| المجسات النانوية Nanosensors |
البحث والتطوير | ||||
| الڤيروس المحلل للورم Oncolytic virus |
التجارب البشرية (Talimogene laherparepvec, reolysin, JX-594), commercialisation (H101) | علاج السرطان، التصوير الطبي | الڤيروس المحلل للورم | ||
| الطب الشخصي Personalized medicine، التسلسل الكامل للجينوم full genome sequencing |
البحث، التجارب[98] | الإجراءات الطبية الغير شخصية، وتشمل طب التجميل | الإجراءات الطبية الشخصية، تسلسل الجينوم أثناء تجارب الأوية | الجينوم الشخصي | |
| الأجسام المضادة النباتية Plantibody |
تجارب سريرية | ||||
| الطب التجديدي Regenerative medicine |
بعض التجارب المعملية[99] | إطالة الحياة | |||
| الجراحة الروبوتية Robotic surgery |
البحث، الانتشار[100][101][102] | الجراحون الغير مدربون في الجراحة الروبوتية | |||
| العلاج بالخلايا الجذعية Stem cell treatments |
البحث، التجارب، المرحلة الأولى من التجارب على البشر لعلاج إصابات العمود الفقري، زراعات القرنية[103][104] | علاجات أخرى | علاج مجموعة متنوعة من الأمراض والإصابات | الخلايا الجذعية، [[علاج الخلايا الجذعية|علاجات الخلايا الجذعيةي]، Skin cell gun | |
| علم الأحياء التركيبي Synthetic biology، علم الجينوم التركيبي synthetic genomics |
البحث، التطوير، تم تخليق أول جراثيم تركيبية في مايو 2010[105][106] | الصناعة الكيميائية، صناعة النفط، عملية التصنيع | إنشاء عمليات إنتاج قابلة للتطوير بشكل لا نهائي بناءاً على الأنواع القابلة للبرمجة من الجراثيم وأشكال حياة أخرى. | بيوبريك، الآلة المهندسة وراثياً عالمياً، المواد التخليقية، علم الجينوم | |
| هندسة الأنسجة Tissue engineering |
البحث، الانتشار[107][108][109][110] | طباعة الأعضاء، زراعة الأسنان | |||
| Tricorder | البحث والتطوير | الفحوصات الطبية | تشخيص الحالات الطبية | Medical tricorder | |
| العلاج بالڤيروسات Virotherapy |
البحث، التجارب على البشر | العلاج الوراثي، علاج السرطان | العلاج بالڤيروسات، الڤيروس المحلل للورم | ||
| التزجيج Vitrification أو الواقي من التجمد cryoprotectant |
افتراضي، بعض التجارب[111] | أضرار نقص التروية | زراعة الأعضاء، حفظ الخلايا الحية بالتبريد |
العلوم العصبية
| التقنية الناشئة | صورة | الحالة | قد تحل محل | التطبيقات المحتملة | مقالات متعلقة |
|---|---|---|---|---|---|
| واجهة الدماغ-حاسوب Brain-computer interface |
البحث، التسويق التجاري | ألعاب الڤيديو، التلفزيون، الأفلام وأجهزة الاتصالات ونقل البشر الحالية. | اتصالات وتعلم أكثر سرعة وترفيه "أكثر واقعية" (توليد المشاعر والمعلومات في الحقل عند الطلب). التحكم في المشاعر في حالات المرض العقلي.[112] | التجربة الآلية، نيورالينك | |
| القراءة العقلية Brain-reading، المعلوماتية العصبية Neuroinformatics |
البحث[113][114] | ||||
| رسم المخ Electroencephalography |
البحث، الانتشار[115] | لوحات المفاتيح والواجهات الأخرى | التحكم في الأجهزة الإلكترونية عن طريق الموجات العقلية | برينگيت | |
| زراعة الرأس Head transplant |
نجحت في تجارب على الحيوانات، ومن بينها عمليتين لزراعة الرأس؛ أجريت جراحة لزراعة رأس بشرية في أوائل 2017. | الحفظ بالتبريد | لعلاج الأمراض المنهكة أو التشوهات الشديدة. | زراعة المخ، زراعة الأيدي، زراعة الأعضاء | |
| Neuroprosthetics | Visual prosthesis، زراعة المخ، واجهة الدماغ-حاسوب، زراعة الشبكية |
العسكرية
الفضاء الخارجي
| التقنية الناشئة | صورة | الحالة | قد تحل محل | التطبيقات المحتملة | مقالات متعلقة |
|---|---|---|---|---|---|
| الجاذبية المضادة Anti-gravity |
افتراضية، تجارب[122][123] | ||||
| الجاذبية الاصطناعية Artificial gravity |
البحث والتطوير | السفر عبر الفضاء | |||
| التعدين الفضائي Asteroid mining |
افتراضية، أعلنت ناسا عن خطط للاستحواذ على كويكب واعادة توجيهه.[124] | ||||
| المجهر الفائق Hypertelescope |
افتراضية | علم الفلك | |||
| غرفة الركود Stasis Chamber | التجارب، البحث والتطوير[125] | السفر الفضائي التقليدي | السفر الفضائي بين الكواكب، السفر الفذائي بين النجوم، الطب | ||
| عدسات الجاذبية الشمسية Solar gravitational lens |
افتراضية | رصد الفضاء العميق | فوكال | ||
| موئل الفضاء المطاطي Inflatable space habitat |
تم تطويره، نماذج أولية تم انشائها واختبارها | وحدات سكان الفضاء "علبة الألومنيوم" التقليدية | السكن في الفضاء | بيگلو للطيران الفضائي | |
| الساتل المصغر Miniaturized satellite |
البحث، التطوير، بعض النماذج الأولية | السواتل التقليدية | السواتل الرخيصة، أبراج الاتصالات ذات معدل البيانات المنخفض، استخدام التشكيلات لجمع البيانات من نقاط متعددة، الفحص المداري للسواتل الأكبر |
الروبوت
| التقنية الناشئة | الحالة | قد تحل محل | التطبيقات المحتملة | مقالات متعلقة |
|---|---|---|---|---|
| أندرويد Android، جينويد gynoid |
البحث، التطوير، النماذج الأولية، الانتشار، التسويق التجاري [126] | البشر | رعاية المعاقين والرضع وكبار السن، التدبير المنزلي، عمال الجنس، مضيفات الطيران، العارضون، المذيعون، الندلة، حراس الأمن | |
| التقنية النانوية الجزيئية Molecular nanotechnology، الروبوتية النانوية nanorobotics |
افتراضية، التجارب[127] | إنتاج المنتجات وقطع الغيار وتوزيع التجزئة | الآلات (المكتبية، الصناعية) التي يمكنها صنع أي شيء من المواد المعطاة (مثل روتيماتيك) التشكل الأرضي الكوكبي الزهيد. | |
| الهيكل الخارجي الآلي Powered exoskeleton |
البحث، التطوير، النماذج الأولية، الانتشار، التسويق التجاري[128] | الكراسي المتحركة الكهربائية، رافعات الشوكة | الرفع الثقيل، الشلل، الأمراض المتعلقة بالعضلات، الحروب، الانشاءات، إطفاء الحرائق، رعاية كبار لاسن والمعاقين. | لوپيس (هيكل خارجي)، ريواك، حامل الحمولة العالمية البشرية، درع الرجل الحديدي الخيالي، محارب قوة المستقبل |
| Self-reconfiguring modular robot | افتراضية، التجارب، النماذج الأولية المبكرة | طرق أخرى لتشكيل البنى الفيزيائية والآلات | كآلة فيزيائية عالمية، قد تغير التقنية في طريقة صنعنا للكثير من البنى الفيزيائية والآلات. | الروبوت، روبوتية الأسراب، روبوت البحث الذاتي |
| روبوتية الأسراب Swarm robotics |
افتراضية، التجارب[129] | الحوسبة الموزعة، تعقيد السلوك بتبسيط العمارة | الانشاءات الذاتية، الانشاءات الفضائية | ذكاء السرب، الروبوتية الذاتية، النانوروبوت، تحسين سرب الجسيمات، الأنظمة متعددة العوامل، الروبوتية السلوكية |
| المركبات الغير مأهولة Unmanned vehicles |
البحث والتطوير، الانتشار، والتسويق التجاري | المراكب المأهولة، التجسس البشري، السفن، المطابخ، المطاعم (نقل السلع الغير مأهول) | نقل السلع (مثل الأغذية)، مراقبة الجمهور، التنصت، علم المحيطات، مراقبة الماشية جوياً على النطاق التجاري، رسم خرائط للحرائق البرية، تأمين خطوط الأنابيب، الأمن القومي، الدوريات على الطرق ومحاربة القرصنة، دوريات الحدود، الكشافة، مطاردة الهاربين، التنقيب وإنتاج النفط والغاز والمعادن، المسوحات الجغرافية، المسوحات الجيومغناطيسية، البحث العلمي في المناطق شديدة الخطورة للطيارين مثل مطاردي العواصف، إطفاء الحرائق،[130] العمليات العسكرية وعمليات حفظ السلام، البحث والإنقاذ، إبطال القنابل والمتفجرات، حراس البوابات وعمليات نقاط التفتيش، حضور الشارع الحضري، وغارات الشرطة في المناطق الحضرية. | مركبة جوية غير مأهولة، أيروڤيرونمنت، الراصد العالمي أيروڤيرونمنت، أيروڤيرونمنت نانو، الطنان، مركبة جوية قتالية غير مأهولة، مركبة برية غير مأهولة، مركبة فضائية غير مأهولة، مركبة سطحية غير مأهولة، مركبة تحت الماء غير مأهولة، مركبة تحت الماء ذاتية |
النقل
| التقنية الناشئة | الحالة | قد تحل محل | التطبيقات المحتملة | مقالات متعلقة | |
|---|---|---|---|---|---|
| الإطار اللاهوائي Airless tire |
النقل | البحث، التطوير، النماذج الأولية المبكرة[131][132] | الإطارات التقليدية | إطارات أكثر أماناً | الإطار-العجلة |
| مركبة الوقود البديل Alternative fuel vehicle |
النقل | التسويق التجاري، الانتشار | محرك احتراق داخلي | تقليل تلوث الهواء، الحد من استهلاك النفط | مركبة كهربائية، مركبة هيدروجينية، مركبة الهواء المضغوط |
| دفع الطاقة الموجهة Beam-powered propulsion |
النقل | افتراضية | الصواريخ | دفع الليزر | |
| الدفع الهيدروديناميكي الكهربائي Ionocraft |
النقل | البحث، التطوير، النماذج الأولية[133][134] | السيارة الطائرة، "هوڤربورد" | نقل جوي أفضل، دفع هوائي أكثر كفاءة | Electrohydrodynamics |
| الأجنحة الثابتة Flexible wings (X-53 Active Aeroelastic Wing, Adaptive Compliant Wing), fluidic flight controls |
النقل | التجارب، النماذج الأولية[135][136][137][138][139] | أنظمة التحكم الجوية الأخرى: الجنيحات، المصاعد، الروافع الخلفية، الجنيحات المتحركة، flaperons | التحكم بالطائرات والسفن | نظام التحكم بالطيران، ديمون لأنظمة الطيران، fluidics |
| السيارة الطائرة Flying car |
النقل | التسويق التجاري المبكر، النماذج الأولية[140][141] | الطائرات، السيارات، الطرق | نقل أكثر كفاءة | ترافوگيا للنقل، Moller M400 Skycar، Urban Aeronautics X-Hawk، أيروموبيل |
| صاروخ الانصهار Fusion rocket |
النقل | البحث، التطوير[142] | الصواريخ الكيميائية | سفر أكثر سرعة بين الكواكب، مع تطبيقات محدود في السفر بين النجوم | |
| Hoverbike | النقل | العمل على النماذج الأولية، التسويق التجاري المبكر | السيارات، الدراجات البخارية، الدراجات البخارية المنخفضة، الدراجات | تسليم الطرود، البحث والإنقاذ | |
| Hovertrain, Ground effect train | النقل | البحث، التطوير[143][144] | القطارات التقليدية | قطارات بسرعة عالية | القطار الهوائي، Duke Hospital PRT، Hovercraft |
| المنصات عالية الارتفاع High Altitude Platforms |
النقل | المرحلة التجريبية | معظم السواتل، أبراج الهواتف المحمولة | الاتصالات | |
| حزام الطيران Jet pack أو backpack helicopter |
النقل | Early commercialization, prototypes[145] | السيارات | نقل أكثر فعالية | |
| القطار المغناطيسي المعلق Maglev train، قطار الأنبوب المفرغ Vactrain |
النقل | البحث، التسويق التجاري المبكر[146][147][148] | القطارات والعجلات التقليدية | قطارات ذات سرعات عالية | النقل السريع، قطار شانغهاي المغناطيسيا لمعلق، لينيمو |
| التعليق المغناطيسي Magnetic levitation |
النقل | البحث، التطوير، التسويق التجاري (القطار المغناطيسي المعلق) | العجلات، الإطارات الهوائية، أنظمة النقل التقليدية | الموصلية الفائقة مرتفعة الحرارة، علم التبريد، درجات الحرارة المنفخضة، المبردات، تصميم وعمل المغناطيسات فائقة التوصيل، اللدائن المعززة بالألياف للمركبات والخرسانة الهيكلية، الاتصالات والتحكم في المواد الصلبة عالية الطاقة، تصميم المركبات، التصنيع الدقيق، إنشاء وتصنيع الهياكل الخرسانية،[149] maglev car, maglev based spacecraft launch | قطار الأنبوب المفرغ، Levicar |
| المسترجم Mass driver |
النقل | نماذج أولية | الصواريخ | ||
| الطفو للمدار Float to Orbit |
النقل | افتراضية | الإطلاق الفضائي التقليدي | الإطلاق الفضائي | |
| الصاروخ الفوتوني النووي Nuclear photonic rocket |
النقل | افتراضية | الصواريخ الأيونية | السفر عبر الكواكب | |
| النقل السريع الشخصي Personal rapid transit |
النقل | الانتشار، التسويق التجاري المبكر[150][151] | السيارات | نقل أكثر تأثيراً | مورجانتاون للنقل السريع الشخصي، ألترا |
| صاروخ الفوتون Photon rocket |
النقل | افتراضية | الصواريخ الكيميائية | السفر عبر النجوم | |
| الإنترنت المادي Physical Internet |
النقل | الأبحاث[152] | اللوجستيات التقليدية | ||
| نظام مشاركة السكوتر Scooter-sharing system |
النقل | التسويق التجاري | السيارات | كثافة متزايدة[153] | بيرد (شركة) |
| قطار الأنبوب المفرغ Vactrain |
النقل | البحث، التطوير | قطار عالي السرعة | وسيلة سريعة للذهاب إلى أي مكان | ET3 Global Alliance، هايپرلوپ |
| مستودع الدفع Propellant depot |
النقل | البحث، التطوير | صواريخ الرفع الثقيل | تمكين مهمات الفضاء العميق ذات الحمولات الثقيلة، إطالة عمر السواتل، انخفاض في تكلفة الإطلاق الفضائي لكل كيلوگرام من الحمولة | |
| محرك التفجير النابض Pulse detonation engine |
النقل | عروض تجريبية | الصواريخ الكيميائية | سفر أسرع بين الكواكب، مع إمكانية محتملة لتطبيقه على السفر بين النجوم | |
| نظام إطلاق قابل لإعادة الاستخدام Reusable launch system |
النقل | البحث، التسويق التجاري المبكر | نظام اطلاق متعدد المراحل | النقل من السطح للمدار | برنامج سپيسإكس لتطوير نظام اطلاق يعاد استخدامه، بي إف آر |
| المصعد الفضائي Space elevator |
النقل | البحث، التطوير[154] | الإنطلاق الفضائى اللاصاروخى، الحلقة المدارية، سكاي هوك، النافورة الفضائية | ||
| الطائرة الفضائية Spaceplane |
النقل | البحث والتطوير[155][156][157] | خطوط الطيران التقليدية | نقل فرط صوتي | إيه2، سكايلون |
| نقل أسرع من الصوت Supersonic transport |
النقل | التسويق التجاري، النقل | خطوط الطيران التقليدية | خطوط طيران بسرعة أعلى | كونكورد، توپولڤ تييو-144 |
| أنظمة اتصالات المركبات Vehicular communication systems |
النقل | البحث والتطوير وبعض الانتشار | سلامة السيارات | vehicle safety obstacle inform others warnings on entering intersections, تنظيم المرور لسيارات الإسعاف، سيارات الإطفاء، وسيارات الشرطة إلى وضع معين مثل الملاحقات الساخنة وسوء الأحوال الجوية، نظم مساعدة السائق، الطرق السريعة المؤتمتة. | راكب اصطناعي، الاتصالات قصيرة المدى المخصصة، نظام النقل الذكي |
الزراعة
| التقنية الناشئة | صورة | الحالة | قد تحل محل | التطبيقات المحتملة | مقالات متعلقة |
|---|---|---|---|---|---|
| الروبوت الزراعي Agricultural robot[158] |
البحث والتطوير، المشروعات التجريبية | ||||
| النظم البيئية المغلقة[159][160][161] Closed ecological systems |
الأبحاث، التنمية، ومظاهر العمل مثل بيوسفير 2) | العلوم الزراعية | الزراعة، البحث العلمي، استعمار الفضاء | دفيئة زراعية، بيوسفير 2، مشروع عدن، ملاذ حيوي، دفيئة زراعية بحرية، نظام دفيئة الحصاد الأبدي | |
| اللحم المستنبت Cultured meat |
البحث والتطوير[162][163] | تربية الماشية، صيد الأسماك[163] | الحصول على لحوم بطرق أكثر إنسانية، كفاية في الموارد، وأرخص سعراً [163] | نيو هارڤست | |
| الزراعة الدقيقة Precision agriculture |
البحث والتطوير، الانتشار | ||||
| المزرعة الرأسية Vertical farming |
البحث، التطوير، التجارب، والانتشار[164][165][166] | الزراعة الصناعية | انتاج الحاصلات واللحوم |
انظر أيضاً
- عام:قائمة المخترعين، قائمة المخترعات، بيئة صناعية، تنمية مستدامة
- نانو: علوم النانو، تصنيع جزيئي، تقنية النانو
- أخلاقيات: احتيال شرعي، أخلاقيات الهندسة، أخلاقيات النانو، أخلاقيات حيوية، أخلاقيات عصبية
- حواسب: واجهة الدماغ-حاسوب، أخلاقيات الحاسوب، حاسوب متين، حاسوب محمول باليد، واقع افتراضي
- أخرى: توجيه آلي، تحديد الهوية بموجات الراديو، المؤسسة الوطنية للعلوم، حاوية المخلفات الأوتوماتيكية
الهوامش
- IEEE International Conference on Emerging Technologies and Factory Automation, & Fuertes, J. M. (1999). 1999 7th IEEE International Conference on Emerging Technologies and Factory Automation proceedings, ETFA'99, October 18-21, 1999, UPC, Barcelona, Catalonia, Spain. Piscataway, N.J.: Institute of Electrical and Electronics Engineers.
- Jones-Garmil, K. (1997). The wired museum: Emerging technology and changing paradigms. Washington, DC: American Association of Museums.
- Giersch, H. (1982). Emerging technologies: Consequences for economic growth, structural change, and employment : symposium 1981. Tübingen: Mohr.
المصادر
- ^ C. Epstein - [1] published by AIN online December 3, 2015 [Retrieved 2015-12-04]
- ^ "Starlink". SpaceX.
{{cite web}}: CS1 maint: url-status (link) - ^ "10 BREAKTHROUGH TECHNOLOGIES 2018". technologyreview. 2018-06-05. Retrieved 2018-06-06.
- ^ "World's first climate-controlled domed city to be built in Dubai. (PHOTOS)". rt.com.
- ^ "Sto AG, Cabot Create Aerogel Insulation". Construction Digital. 15 نوفمبر 2011. Archived from the original on 31 ديسمبر 2011. Retrieved 18 نوفمبر 2011.
{{cite news}}: Unknown parameter|deadurl=ignored (|url-status=suggested) (help) - ^ "Is graphene a miracle material?". BBC Click. 21 May 2011. Retrieved 18 November 2011.
- ^ "Could graphene be the new silicon?". The Guardian. 13 November 2011. Retrieved 18 November 2011.
- ^ "Applications of Graphene under Development". understandingnano.com.
- ^ "The 'new age' of super materials". BBC News. 5 March 2007. Retrieved 27 April 2011.
- ^ "Strides in Materials, but No Invisibility Cloak". The New York Times. 8 November 2010. Retrieved 21 April 2011.
- ^ NAE Website: Frontiers of Engineering Archived 28 يوليو 2014 at the Wayback Machine. Nae.edu. Retrieved 22 February 2011.
- ^ "Carbon nanotubes used to make batteries from fabrics". BBC News. 21 January 2010. Retrieved 27 April 2011.
- ^ "Researchers One Step Closer to Building Synthetic Brain". Daily Tech. 25 April 2011. Retrieved 27 April 2011.
- ^ "Pentagon Developing Shape-Shifting 'Transformers' for Battlefield". Fox News. 10 June 2009. Retrieved 26 April 2011.
- ^ "Intel: Programmable matter takes shape". ZD Net. 22 August 2008. Retrieved 2 January 2012.
- ^ "'Quantum dots' to boost performance of mobile cameras". BBC News. 22 March 2010. Retrieved 16 April 2011.
- ^ Richerme, Phil (2017-01-18). "Viewpoint: How to Create a Time Crystal". Physics (in الإنجليزية الأمريكية). 10.
- ^ "3D display technology is no headache, claim researchers". The Engineer. 5 April 2011. Retrieved 17 April 2011.
- ^ "Scientist: Holographic television to become reality". CNN. 7 October 2008. Retrieved 29 April 2011.
- ^ "Holographic video takes step forward with updated display". The Independent. 5 November 2010. Retrieved 29 April 2011.
- ^ "Phone calls in 3-D soon". New Straits Times. 9 January 2011. Retrieved 29 April 2011.[dead link]
- ^ "Natural iridescence harnessed for reflective displays". EE Times. 26 July 2009. Retrieved 5 May 2011.
- ^ "LG set to sell 55-inch TV using new OLED technology". Taipei Times. 2 January 2012. Retrieved 3 January 2011.
- ^ "LG Announces 4K OLED TVs For Sale". Forbes. 25 August 2014. Retrieved 31 August 2014.
- ^ "Our first look at Samsung's massive 146-inch 4K MicroLED TV". Engadget (in الإنجليزية الأمريكية). Retrieved 2018-02-01.
- ^ Mu-Hyun, Cho. "Samsung's Micro LED bet will define its future in TVs | ZDNet". ZDNet (in الإنجليزية). Retrieved 2018-02-01.
- ^ McManamon P.F.; et al. (15 May 1996). "Optical phased array technology". Proceedings of the IEEE, Laser radar applications. IEEE. 84 (2): 99–320. Retrieved 29 April 2011.
- ^ Wowk B (1996). "Phased Array Optics". In BC Crandall (ed.). Molecular Speculations on Global Abundance. MIT Press. pp. 147–160. ISBN 0-262-03237-6. Retrieved 29 April 2011.
- ^ "Tuberculosis breakthrough as scientists get funds for 'electronic nose'". The Guardian. 7 November 2011. Retrieved 4 December 2011.
- ^ "Now, a mobile phone that can smell". The Times of India. 7 November 2011. Retrieved 4 December 2011.
- ^ "Electronic Cotton". IEEE Spectrum. January 2012. Retrieved 4 March 2012.
- ^ "Remapping Computer Circuitry to Avert Impending Bottlenecks". The New York Times. 28 February 2011. Retrieved 27 April 2011.
- ^ "Memristor revolution backed by HP". BBC News. 2 September 2010. Retrieved 27 April 2011.
- ^ U.S. Patent 7٬203٬789
- ^ U.S. Patent 7٬302٬513
- ^ U.S. Patent 7٬359٬888
- ^ U.S. Patent 7٬609٬086
- ^ U.S. Patent 7٬902٬857
- ^ U.S. Patent 7٬902٬867
- ^ U.S. Patent 8٬113٬437
- ^ "Memristor Models for Pattern Recognition Systems". springer.com.
- ^ "Scientists developing spintronic computer chips". The Times of India. 14 April 2011. Retrieved 17 April 2011.
- ^ "Getting wind farms off the ground". The Economist. 7 June 2007. Retrieved 7 December 2011.
- ^ "Wind turbines take to the skies". BBC News. 3 June 2010. Retrieved 7 December 2011.
- ^ "Airborne Wind Turbines". The New York Times. 9 December 2007. Retrieved 7 December 2011.
- ^ "Solar 'Artificial Leaf' Is Unveiled by Researchers". Reuters. 29 March 2011. Retrieved 21 April 2011.
- ^ Faunce TA, Lubitz W, Rutherford AW, MacFarlane D, Moore, GF, Yang P, Nocera DG, Moore TA, Gregory DH, Fukuzumi S, Yoon KB, Armstrong FA, Wasielewski MR, Styring S. Energy and Environment Case for a Global Project on Artificial Photosynthesis. Energy and Environmental Science (2013) DOI: 10.1039/c3ee00063j http://pubs.rsc.org/en/content/articlelanding/2013/ee/c3ee00063j (accessed 2 June 2013)
- ^ "California approves Tessera solar plant". Reuters. 28 October 2010. Retrieved 4 May 2011.
- ^ "Ultracapacitors Gain Traction as Battery Alternative". Reuters. 30 March 2011. Retrieved 4 May 2011.
- ^ "MIT develops way to bank solar energy at home". Reuters. 31 July 2008. Retrieved 24 December 2011.
- ^ "All eyes on Bloom Box fuel cell launch". The Guardian. 22 February 2010. Retrieved 24 December 2011.
- ^ "Japan aims its home fuel cells at Europe". BBC News. 12 March 2010. Retrieved 24 December 2011.
- ^ Kraytsberg A, Ein-Eli Y (2011). "Review on Li-air batteries - Opportunities, limitations and perspective". Journal of Power Sources,196:p.886-893.
- ^ "Scientists say paper battery could be in the works". Reuters. 7 December 2009. Retrieved 4 May 2011.
- ^ "Microfiber fabric makes its own electricity?". Reuters. 14 February 2008. Retrieved 4 May 2011.
- ^ "A new device to tap more solar energy invented". The Hindu. 18 May 2011. Retrieved 24 December 2011.
- ^ "Heat scavenging - Stealing the heat". The Economist. 4 March 2010. Retrieved 24 December 2011.
- ^ "New Rays". Businessworld. 21 May 2011. Retrieved 24 December 2011.[dead link]
- ^ "Electricity to power 'smart grid'". BBC News. 18 May 2009. Retrieved 4 March 2012.
- ^ "Smart Grid Costs Are Massive, but Benefits Will Be Larger, Industry Study Says". The New York Times. 25 May 2011. Retrieved 4 March 2012.
- ^ "Pushing the low carbon boundaries: South Korea's smart grid initiative". The Guardian. 5 September 2011. Retrieved 4 March 2012.
- ^ "Wireless energy promise powers up". BBC News. 7 June 2007. Retrieved 4 May 2011.
- ^ "FCC approves first wireless 'power-at-a-distance' charging system". Engadget. 27 Dec 2017. Retrieved 27 Dec 2017.
- ^ Parag and Ayesha Khanna. "Do We Need Actors? CGI and the Future of Hollywood". Big Think.
- ^ أ ب "The big plan to build a brain". The Telegraph. 21 June 2011. Retrieved 18 November 2011.
- ^ "IBM's Watson supercomputer crowned Jeopardy king". BBC News. 17 February 2011. Retrieved 17 April 2011.
- ^ "MIT scientists take a step closer to artificial intelligence". Computer Weekly. 18 November 2011. Retrieved 18 November 2011.
- ^ "How innovative is Apple's new voice assistant, Siri?". New Scientist. 3 November 2011. Retrieved 4 March 2012.
- ^ World Economic Forum’s Meta-Council on Emerging Technologies (2016). "Top 10 Emerging Technologies of 2016" (PDF). World Economic Forum. Retrieved 21 September 2016.
- ^ UK Government Chief Scientific Officer (December 2015). "Distributed Ledger Technology: beyond block chain" (PDF). gov.uk. UK Government. Retrieved 21 September 2016.
- ^ "The People Who Burn Bitcoins". Minyanville. 16 April 2014. Retrieved 20 June 2014.
- ^ "G.E.'s breakthrough can put 100 DVDs on a disc". Tehran Times. 28 April 2009. Retrieved 29 April 2011.
- ^ "eyeSight CEO Gideon Shmuel: The Company Making Minority Report A Reality (Finally)". The Huffington Post. 30 July 2012. Retrieved 31 July 2012.
- ^ "Get Sampark, go multilingual". The Hindu. 3 April 2011. Retrieved 29 April 2011.
- ^ "Mobile Video Collaboration System Securely Connects Field Staff and Experts". Electronic Component News. 28 مارس 2011. Archived from the original on 1 أكتوبر 2011.
{{cite news}}: Italic or bold markup not allowed in:|publisher=(help); Unknown parameter|deadurl=ignored (|url-status=suggested) (help) - ^ "New hand-held device targets work on shop floor: veteran high-tech team launches new venture". Winnipeg Free Press. 11 July 2005.
{{cite news}}: Italic or bold markup not allowed in:|publisher=(help) - ^ "US scientists build first 'antilaser'". ABC. 18 February 2011. Retrieved 21 April 2011.
- ^ "Quantum computing device hints at powerful future". BBC News. 22 March 2011. Retrieved 17 April 2011.
- ^ "First Ever Commercial Quantum Computer Now Available for $10 Million". ExtremeTech. 20 May 2011. Retrieved 22 May 2011.
- ^ "Does quantum mechanics offer the best way to protect our most valuable data?". The Independent. 31 March 2011. Retrieved 17 April 2011.
- ^ "Will NFC make the mobile wallet work?". BBC News. 7 October 2011. Retrieved 8 December 2011.
- ^ "Internet of things: Should you worry if your jeans go smart?". BBC News. 23 September 2011. Retrieved 8 December 2011.
- ^ "RFID tagging: Chips with everything". The Telegraph. 20 May 2009. Retrieved 8 December 2011.
- ^ Adams, R., Mann, G., & Hobbs, V. (2017). ISEEK, a tool for high speed, concurrent, distributed forensic data acquisition. Paper presented in Valli, C. (Ed.). The Proceedings of 15th Australian Digital Forensics Conference 5-6 December 2017, Edith Cowan University, Perth, Australia DOI 10.4225/75/5a838d3b1d27f [2]
- ^ "A giant leap into the unknown: GM salmon that grows and grows". The Independent. 22 September 2010. Retrieved 5 May 2011.
- ^ "Gene therapy is cure for 'boy in the bubble' syndrome". The Telegraph. 24 August 2011. Retrieved 18 November 2011.
- ^ "U.S. Super Soldiers Of The Future Will Be Genetically Modified Transhumans Capable Of Superhuman Feats". endoftheamericandream.com.
- ^ Joseph Stromberg. "Genetically Modified E. Coli Bacteria Can Now Synthesize Diesel Fuel". Smithsonian.
- ^ "Genetic Engineering Boosts Ethanol Production by 50 Percent - MIT Technology Review". MIT Technology Review.
- ^ "USU Synthetic Spider Silk Lab awarded $1.9 million in DOE Energy Efficient Transportation Technology Funds". CacheValleyDaily.com.
- ^ Shivani Sharma. "Application of Genetic Engineering in Bioremediation: Deinococcus Radiodurans". biotecharticles.com.
- ^ Katharine Sanderson. "New Portable Kit Detects Arsenic In Wells". acs.org.
- ^ "Patients to be frozen into state of suspended animation for surgery". The Telegraph. 26 September 2010. Retrieved 21 April 2011.
- ^ "Doubt on Anti-Aging Molecule as Drug Trial Stops". The New York Times. 10 January 2011. Retrieved 1 May 2011.
- ^ "Signs of ageing halted in the lab". BBC News. 2 November 2011. Retrieved 16 December 2011.
- ^ "Aiming for clinical excellence". The Guardian. 26 November 2011. Retrieved 16 December 2011.
- ^ "Nanotechnoglogy world: Nanomedicine offers new cures". The Guardian. 6 September 2011. Retrieved 16 December 2011.
- ^ "Genetic test could be used to 'personalise' drugs, say scientists". The Independent. 1 March 2010. Retrieved 16 April 2011.
- ^ "Scientists Grow Viable Urethras From Boys' Cells". Fox News. 8 March 2011. Retrieved 27 April 2011.
- ^ "Doctors grapple with the value of robotic surgery". Houston Chronicle. 16 September 2011. Retrieved 24 December 2011.
- ^ "Robotic surgery making inroads in many medical procedures". The Jakarta Post. 8 March 2011. Retrieved 24 December 2011.
- ^ "Doctors Perform First Fully Robotic Surgery". PC World. 21 October 2010. Retrieved 24 December 2011.
- ^ "Scientists make eye's retina from stem cells". BBC News. 6 April 2011. Retrieved 27 April 2011.
- ^ "Medical marvels". The Guardian. 30 January 2009. Retrieved 16 December 2011.
- ^ "'Artificial life' breakthrough announced by scientists". BBC News. 20 May 2010. Retrieved 29 April 2011.
- ^ "Scientist Craig Venter creates life for first time in laboratory sparking debate about 'playing god'". The Telegraph. 20 May 2010. Retrieved 29 April 2011.
- ^ "Artificial blood vessels created on a 3D printer". BBC News. 16 September 2011. Retrieved 26 December 2011.
- ^ "Penis tissue replaced in the lab". BBC News. 10 November 2009. Retrieved 26 December 2011.
- ^ "U.S. scientists create artificial lungs, of sorts". Reuters. 24 June 2010. Retrieved 26 December 2011.
- ^ "Silkworms could aid a breakthrough in tissue engineering". BBC News. 15 December 2011. Retrieved 26 December 2011.
- ^ "Research updates: CMU prof wins grants for very cool technology". Pittsburgh Post-Gazette. 11 August 2010. Retrieved 18 November 2011.
- ^ "DARPA Program Seeks to Use Brain Implants to Control Mental Illness - MIT Technology Review". MIT Technology Review.
- ^ "Mind-reading research: the major breakthroughs". The Telegraph. 22 September 2011. Retrieved 18 November 2011.
- ^ "'Mind-reading device' recreates what we see in our heads". The Telegraph. 22 September 2011. Retrieved 18 November 2011.
- ^ "'Mind Control' Possible in 5 Years: IBM". NBC Bay Area. 21 December 2011. Retrieved 21 December 2011.
- ^ Rachel Kaufman (28 January 2011). "New Invisibility Cloak Closer to Working "Magic"". National Geographic News. Retrieved 4 February 2011.
- ^ "Laser gun tested on US Navy ship in Pacific Ocean". BBC News. 11 April 2011. Retrieved 18 April 2011.
- ^ "Electromagnetic weapons - Frying tonight". The Economist. 15 October 2011. Retrieved 19 November 2011.
- ^ "Navy Sets World Record With Incredible, Sci-Fi Weapon". Fox News. 10 December 2010. Retrieved 19 November 2011.
- ^ "Star Trek-style force-field armour being developed by military scientists". The Telegraph. 20 March 2010. Retrieved 16 April 2011.
- ^ "Navy tests new vehicle-mounted laser weapon". 29 September 2014.
- ^ "BAe's anti-gravity research braves X-Files ridicule". The Guardian. 27 March 2000. Retrieved 4 December 2011.
- ^ "Boeing joins race to defeat gravity". The Telegraph. 30 July 2002. Retrieved 4 December 2011.
- ^ "New Imagery of Asteroid Mission". NASA.
- ^ "Spaceworks may have a real-world stasis chamber for space travel by 2018". Digital Trends (in الإنجليزية الأمريكية). 2017-01-29. Retrieved 2017-02-01.
- ^ "SoftBank robot to reach US in less than a year". TechnologyTell.
- ^ "Tiny motors may be big in surgery". BBC News. 20 January 2009. Retrieved 21 April 2011.
- ^ Christopher Mims (2009). "Exoskeletons Give New Life to Legs". Scientific American. Retrieved 21 April 2009.
- ^ "Riders on a swarm". The Economist. 12 August 2010. Retrieved 21 April 2011.
- ^ Sharon Gaudin (2 April 2014). "U.S. Navy to test humanoid robotic firefighters". Computerworld.
- ^ "Airless Tire Promises Grace Under Pressure for Soldiers". Scientific American. 11 August 2008. Retrieved 6 December 2011.
- ^ "New tire models to go without air or oil". The Daily Yomiuri. 6 December 2011. Retrieved 6 December 2011.
- ^ "On the performance of electrohydrodynamic propulsion".
- ^ "Electrohydrodynamic effect offers promise for efficient propulsion in air".
- ^ Scott, William B. (27 November 2006), "Morphing Wings", Aviation Week & Space Technology, http://www.aviationweek.com/aw/
- ^ "FlexSys Inc.: Aerospace". Archived from the original on 16 June 2011. Retrieved 26 April 2011.
{{cite web}}: Unknown parameter|deadurl=ignored (|url-status=suggested) (help) - ^ Kota, Sridhar; Osborn, Russell; Ervin, Gregory; Maric, Dragan; Flick, Peter; Paul, Donald. "Mission Adaptive Compliant Wing – Design, Fabrication and Flight Test" (PDF). Ann Arbor, MI; Dayton, OH, U.S.A.: FlexSys Inc., Air Force Research Laboratory. Archived from the original (PDF) on 22 March 2012. Retrieved 26 April 2011.
{{cite web}}: Unknown parameter|deadurl=ignored (|url-status=suggested) (help) - ^ "Showcase UAV Demonstrates Flapless Flight". BAE Systems. 2010. Retrieved 22 December 2010.
- ^ "Demon UAV jets into history by flying without flaps". Metro.co.uk. London: Associated Newspapers Limited. 28 September 2010. Retrieved 29 September 2010.
- ^ "Terrafugia Transition flying car to go into production after US approval". The Australian. 1 July 2010. Retrieved 6 December 2011.
- ^ "Stuck in traffic? Turn your car into a plane in 30 secs". The Times of India. 2 July 2010. Retrieved 6 December 2011.
- ^ "Rocket powered by nuclear fusion could send humans to Mars". 4 April 2013.
- ^ "Flying train unveiled by Japanese scientists". CNN. 13 May 2011. Retrieved 7 December 2011.
- ^ "Robot plane-train uses ground-effect principle to levitate". Wired. 12 May 2011. Retrieved 7 December 2011.
- ^ "Flying into the future: New Zealand company to make personal jet packs". The Telegraph. 24 February 2010. Retrieved 6 December 2011.
- ^ "China scientists claim 1,200 kph train". CNN. 1 February 2011. Retrieved 7 December 2011.
- ^ "Laboratory working on train to run at 1,000 kph". Shanghai Daily. 3 August 2010. Retrieved 7 December 2011.
- ^ "How vactrains work". The Seattle Times. 16 August 2010. Retrieved 7 December 2011.
- ^ "The Potential for Maglev Applications". about.com.
- ^ "Pod Cars Start to Gain Traction in Some Cities". The New York Times. 20 September 2010. Retrieved 7 December 2011.
- ^ "Are driverless pods the future?". BBC News. 18 December 2007. Retrieved 7 December 2011.
- ^ Physical Internet would increase profits, reduce carbon emissions, study finds. Phys.org. Retrieved on 2013-07-21.
- ^ "The Disgraceful Dockless Drama: What Dockless Bikes/Scooters Are Exposing". Have A Go. 2018-04-18. Retrieved 2018-06-04.
- ^ "Robot passes test in space elevator contest". The Washington Post. 5 November 2009. Retrieved 19 November 2011.
- ^ "Plans to develop space-plane are go". The Australian. 20 October 2008. Retrieved 7 December 2011.
- ^ "UK Skylon spaceplane passes key review". BBC News. 24 May 2011. Retrieved 7 December 2011.
- ^ "Air Force says it's extending mission of mysterious X-37B". Los Angeles Times. 29 November 2011. Retrieved 7 December 2011.
- ^ A review of automation and robotics for the bio-industry. Journal of Biomechatronics Engineering Vol. 1, No. 1, (2008) 37-54
- ^ NASA - Investigation of a Closed Ecological System. nasa.gov
- ^ Ben Armentrout, and Heidi Kappes. Studies in Closed Ecological Systems: Biosphere in a Bottle
- ^ Frieda B. Taub Annual Review of Ecology and Systematics Vol. 5, (1974), pp. 139-160
- ^ "Is in vitro meat the future?". The Times. 9 May 2008. Retrieved 7 December 2012.
- ^ أ ب ت "Artificial meat: Hamburger junction". The Economist. 25 February 2012. Retrieved 3 March 2012.
- ^ "Vertical farming - Does it really stack up?". Te Economist. 9 December 2010. Retrieved 18 November 2011.
- ^ "Vertical Farming - Can Urban Agriculture Feed a Hungry World?". Spiegel. 22 July 2011. Retrieved 18 November 2011.
- ^ "Vertical Harvest of Jackson Hole Will Grow Organic Produce Even in Winter". Inhabitat. 6 June 2012. Retrieved 29 August 2013.
وصلات خارجية
- Special Reports 10 Emerging Technologies. Technology Review.
This article contains content from Wikimedia licensed under CC BY-SA 4.0. Please comply with the license terms.